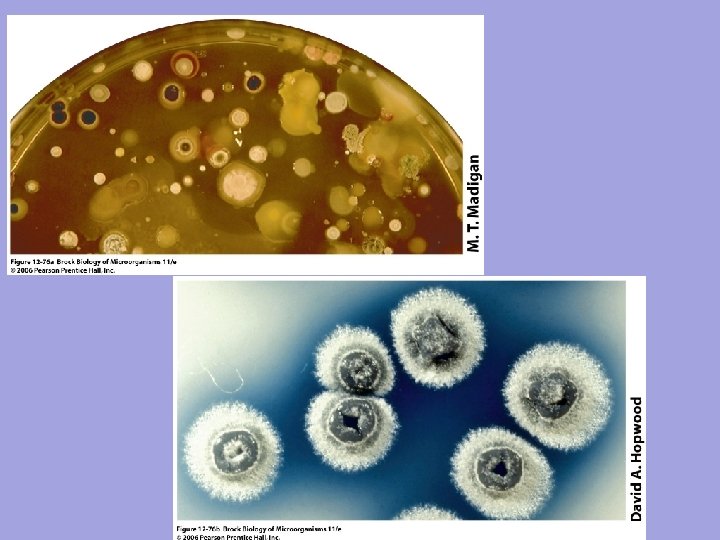

Antibiotics What are antibiotics Who are the main

Antibiotics What are antibiotics? Who are the main producers? Biological functions? Resistance New developments

First antimicrobial drugs Louis Pasteur (1822 -1825): “pasteurization” Fermentation: wine contamination Germ theory: silkworn disease Vaccine: anthrax, fowl cholera Rabies

First antimicrobial drugs Paul Ehrilch (1854 -1915): - Methylene blue: malaria -Toxin and antitoxin -Salvarsan: magic bullet against syphilis, Treponema pallidum

First antimicrobial drugs • Gerhard Domagk (Nobel Prize 1939) Sulfa drugs Prontosil Sulfanilamide, analog of p-aminobenzoic acid (part of folic acid, precursor of nucleic acids) Development of antituberculosis compounds thiosemiccarbasone and isoniazid

1928 Alexander Fleming 1940 Howard Florey Ernst Chain 1954 Cephalosporin C Staphylococcus aureus Figure 20. 1

Salman Waksman, Albert Schatz 1943. Actinomycin Streptomycin

Diminishing returns in finding natural products: Genetics to the rescue?

Primary and secondary metabolism

What are antibiotics? • Secondary metabolites synthesized by some microorganisms • Any compound able to cause a damaged in a target cell

Who are the main producers • Bacteria Gram positive Streptomyces • Fungi • Other bacteria

MICROORGANISMS and BIOACTIVE COMPOUNDS Fungi Bacteria 1% Bacteria 8% 6% Fungi 32% Actinomycetes 93% Antitumorals Bacteria 6% Fungi 30% Actinomycetes 60% Antifungals Actinomycetes 64% Bioactives

BIOACTIVE COMPOUNDS SYNTHESIZED BY ACTINOMYCETES ANTIBACTERIALS Erythromycin Tetracycline Gentamicin ANTITUMORALS ANTIFUNGALS Amphotericin B Nystatin IMUNOSUPRESSANTS Doxorubicin Mitramycin Bleomycin Rapamycin FK 506 INSETICIDES HERBICIDES Espinosin ANTIPARASITICS Bialaphos Avermectins

LIFE CYCLE OF Streptomyces Spores Aerial mycelium Substrate mycelium Production of secondary metabolites (antibiotics, fungicides, antitumorals, . . )

Biological functions of antibiotics? • In the producer: Activators of morphological differentiation, UV protector, communication • In the target microorganism: Toxicity


Total cell count Viable cell count

Total cell count Viable cell count









Narrow spectrum of microbial activity Broad spectrum antibiotic Figure 20. 6 - Overview

Structure of peptidoglycan tetrapeptide

Peptidoglycan sheet in Escherichia coli and Staphylococcus aureus Glycine interbridge in S. aureus

Figure 20. 3 a

Figure 20. 3 b

Figure 20. 7

Figure 20. 4 a

Figure 20. 4 b

Figure 20. 13 - Overview


Injury of plasma membrane of a yeast caused by antifungal drug Figure 20. 5

Figure 20. 16 a

Figure 20. 16 b

Figure 20. 16 c


Figure 20. 22
- Slides: 43